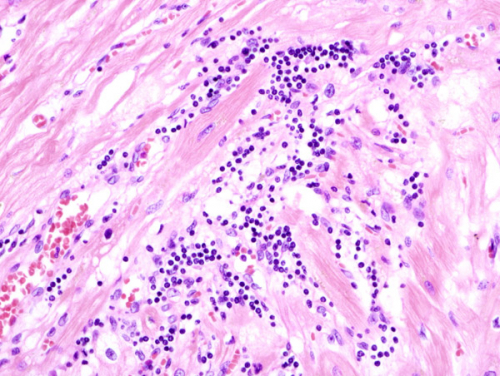

The Spanish National Center for Cardiovascular Research (CNIC) is a leading international research center dedicated to understanding the basis of cardiovascular health and disease and to translating this knowledge into improved patient care.
CNIC scientific area is organized into two departments focused on Basic Research and Clinical Research, fully interconnected through six multidisciplinary programs grouped into three research areas:
1 Vascular Pathophysiology
2 Myocardial Pathophysiology
3 Cell Developmental Biology
Our portfolio include biomarkers, genetic and diagnostic tools, animal models and treatments for cardiovascular, inflammatory and infectious diseases, among others. Some examples of our current projects include treatment for pulmonary hypertension, myeloproliferative diseases and trained immunity for prevention of infections. Regarding diagnosis, we are currently working on biomarkers for myocarditis, subclinical atherosclerosis and calcific aortic valve disease.

Patents for licensing
- +6 months
- Hide post

iSuRe-Cre as a new genetic tool to modify and understand gene function
Patents for licensing
- +6 months
- Hide post

Use of selective Beta-3 adrenergic receptor agonists to treat pulmonary hypertension
Patents for licensing
- +6 months
- Hide post